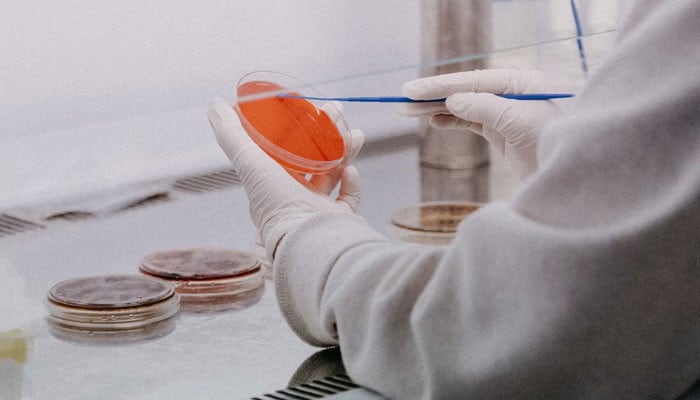

Innovative 3D Printing and Stem Cell Techniques Promise Breakthroughs in Spinal Cord Injury Treatment
Scientists at the University of Minnesota have developed a novel method using 3D-printed scaffolds and stem cells to regenerate nerve fibers across severed spinal cords in rats, showing promising results for future paralysis treatments.